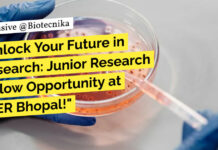
IISER Bhopal Research Recruitment For Biological Sciences, Apply Online Only IISER Bhopal Research Recruitment For Biological Sciences, Apply Online Only

Home 2024
Yearly Archives: 2024
CCMB Life Science & Microbiology Job Opening – Apply Online
CSIR-CCMB Microbiology Job Opening - Life Sciences Apply Online
CSIR-CCMB Microbiology Job Opening - Life Sciences Apply Online. Interested and eligible applicants can check out...
Exciting Opportunity at ICMR-NITVAR For Life Sciences With Rs. 56,000 pm Pay – Apply...
ICMR-NITVAR For Life Sciences With Rs. 56,000 pm Pay - Apply Now
ICMR-NITVAR For Life Sciences With Rs. 56,000 pm Pay - Apply Now. Interested...
RGCB Breast Cancer Project Job For Life Sciences – Apply Online Now
RGCB Cancer Project Job For Life Sciences - Apply Online Now
Temporary Position Available
Advt No. 10/2024
26.07.2024
Applications are invited from suitable candidates (Indian Citizens) for...
Novo Nordisk Life Science Therapy Access Specialist Job Opening – Apply Online
Novo Nordisk Life Science Therapy Access Specialist Job Opening - Apply Online
Therapy Access Specialist
Category: Market Access
Location: Bangalore, Karnataka, IN
Department: Obesity Business Unit
Are you passionate...
HiMedia CellBio Biotech Executive Job Opening – Apply Now
HiMedia CellBio Biotech Executive Job Opening - Apply Now
HiMedia CellBio Biotech Executive Job Opening - Apply Now. Interested and eligible applicants can check out...
Understanding the Challenges Faced By Biotech Freshers Looking For Job + Solutions
Biotech Freshers Challenges
The Biotechnology industry in India is increasing by leaps and bounds. Currently, India is considered among Top 12 destinations for Biotechnology industry...
AIIMS Delhi Agricultural Sciences & Biotech Project Job Opening – Applications Invited
AIIMS Delhi Agricultural Sciences & Biotech Project Job Opening - Applications Invited
Department of Endocrinology & Metabolism
All India Institute of Medical Sciences
VACANCY NOTICE
23rd July, 2024
Detailed...
Biotecnika Times Newsletter 26.07.2024 – Freshers Jobs at Syngene, CSIR NET July Exam Feedback,...
Freshers Jobs at Syngene - Apply Online For Research Associate Role
Apply online for Research Associate roles at Syngene. Freshers are encouraged to apply.
How Was...
Jubilant Biosys MSc & MTech Biotech, Biochem Research Associate Job – Apply Online
Jubilant Biosys Biotech Vacancy, Biochem Research Associate Job - Apply Online
SR. RESEARCH ASSOCIATE I
JOB DESCRIPTION
Jubilant Bhartia Group
Jubilant Bhartia Group is a global conglomerate founded...
Senior Scientist Bioinformatics Job at AstraZeneca – Apply Now!
Bioinformatics Job at AstraZeneca - Apply Now!
AstraZeneca Job Posting: Senior Scientist Bioinformatics
Welcome to AstraZeneca, a pioneering bio-pharmaceutical company dedicated to innovative drug discovery and...
Biocon Biologics R&D Life Sciences Job Opening – Apply Now
Biocon Biologics R&D Life Sciences Job Opening - Apply Now
Research & Development: Opportunities in Characterization Development Lab
Bengaluru, Karnataka, India
About the job
Biocon Biologics is a...
NII Delhi DBT Human Immunology Program Project Research Job For Biological & Life Sciences,...
NII Delhi Project Research Job For Biological & Life Sciences, Apply Now
NATIONAL INSTITUTE OF IMMUNOLOGY
ARUNA ASAF ALI MARG
NEW DELHI
Applications are invited for the one...
Freshers Jobs at Syngene – Apply Online For Research Associate Role
Freshers Vacancies at Syngene - Apply Online For Research Associate Role
Title: Research Associate
Date: 26 Jul 2024
Job Location: Bangalore
Pay Grade: 9-I
Year of Experience: 0 -...
How Was Your CSIR NET Life Science July 2024 Exam? Post Your Feedback!
CSIR NET Life Science July 2024 Exam Survey
Hello Warriors,
The day finally came when you went to the exam hall to attempt the toughest national...
IISER Bhopal Research Recruitment For Biological Sciences, Apply Online Only
IISER Bhopal Research Recruitment For Biological Sciences, Apply Online Only
Indian Institute of Science Education and Research Bhopal
Department of Biological Science
Date: July 25, 2024
Applications are...